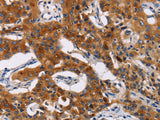
MSLN Polyclonal Antibody Store at -20°C

MSLN Polyclonal Antibody Store at -20°C
SKU: E-AB-10472-200
MSLN Polyclonal Antibody Store at -20°C
| SKU # | E-AB-10472 |
| Reactivity | Human |
| Host | Rabbit |
| Applications | IHC |
Product Details
| Isotype | IgG |
| Host | Rabbit |
| Reactivity | Human |
| Applications | IHC |
| Clonality | Polyclonal |
| Immunogen | Recombinant protein of human MSLN |
| Abbre | MSLN |
| Synonyms | CAK 1, CAK1, CAK1 antigen, MPF, MSLN, Megakaryocyte potentiating factor, Mesothelin, Mesothelin isoform 1 precursor, Msln, Pre pro megakaryocyte potentiating factor, Pre-pro-megakaryocyte-potentiating factor, SMR, SMRP, Soluble MPF mesothelin related prot, cleaved form |
| Swissprot | |
| Cellular Localization | Secreted and Cell membrane. Golgi apparatus. |
| Concentration | 0.4 mg/mL |
| Buffer | Phosphate buffered solution, pH 7.4, containing 0.05% stabilizer and 50% glycerol. |
| Purification Method | Affinity purification |
| Research Areas | Cancer, Immunology, Tags and Cell Markers |
| Conjugation | Unconjugated |
| Storage | Store at -20°C Valid for 12 months. Avoid freeze / thaw cycles. |
| Shipping | The product is shipped with ice pack,upon receipt,store it immediately at the temperature recommended. |
Related Reagents
| Applications | Recommended Dilution |
| IHC | 1:50-1:200 |
Background
This gene encodes a precursor protein that is cleaved into two products, megakaryocyte potentiating factor and mesothelin. Megakaryocyte potentiation factor functions as a cytokine that can stimulate colony formation in bone marrow megakaryocytes. Mesothelian is a glycosylphosphatidylinositol-anchored cell-surface protein that may function as a cell adhesion protein. This protein is overexpressed in epithelial mesotheliomas, ovarian cancers and in specific squamous cell carcinomas. Alternative splicing results in multiple transcript variants.